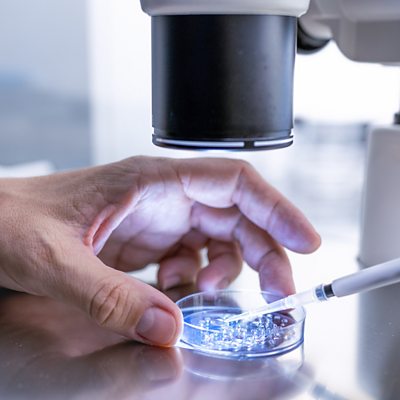

Episode details
Available for over a year
A ruling from the Alabama Supreme Court that frozen embryos are considered children, and that a person could be held liable for accidentally destroying them, has opened up a new front in the US battle over reproductive medicine. We hear how it could affect Alabama’s fertility clinics. Also, in the programme, we will hear about the company driving a global stock market rally. (Picture: Close up In the fertility laboratory the Doctor preparing embryo cultivation plates. Picture credit: Getty Images)
Programme Website